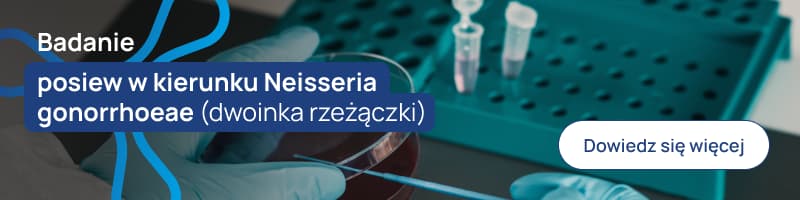
wykrywanie DNA Neisseria gonorrhoeae (dwoinka rzeżączki) met. RT-PCR-1 banerek

Mononukleoza zakaźna (IM – infectious mononucleosis) jest chorobą wirusową potocznie nazywaną chorobą pocałunków. Skąd się wzięło to określenie, co wywołuje mononukleozę, jakie są jej objawy, jak ją zdiagnozować i jak leczyć. Zapraszamy do artykułu.
Spis treści
- EBV – co to za wirus?
- Mononukleoza – objawy
- Diagnostyka mononukleozy
- Główne grupy testów
- Kolejność pojawiania się poszczególnych przeciwciał podczas mononukleozy
- Diagnostyka molekularna mononukleozy
- Leczenie mononukleozy
EBV – co to za wirus?
Wirus Epsteina-Barra (EBV) jest ludzkim wirusem należącym do rodziny Herpesviridae i znany również jako ludzki wirus opryszczki 4 (HHV-4). Zakaża ponad 95% osób dorosłych, które są nosicielami wirusa przez całe życie.
Zakażenie pierwotne zwykle przebiega bezobjawowo, ale może również powodować mononukleozę zakaźną (IM- infectious mononucleosis), występującą najczęściej u dzieci i młodych dorosłych.
Wirus EBV nie jest bardzo zaraźliwy, przenosi się głównie ze śliną, dlatego mononukleoza nazywana jest chorobą pocałunków. Wirus może być przenoszony na inne osoby nawet jeśli infekcja przebiega bezobjawowo, dlatego właściwie nie mamy możliwości zapobiegania rozsiewowi wirusa.
Wirus Epsteina-Barra (EBV) jest wirusem onkogennym, który może wywołać nowotwory nabłonkowe, takie jak:
- rak nosogardła,
- rak żołądka – odpowiedzialny jest za 10% przypadków DAJMY LINK DO RAKA ŻOŁĄDKA
- chłoniaki, w tym chłoniaka Burkitta, chłoniaka Hodgkina, chłoniaka rozlanego z dużych komórek B, chłoniaka z komórek NK/T i potransplantacyjny zespół limfoproliferacyjny.
IM w wywiadzie wiąże się przede wszystkim ze wzrostem ryzyka zachorowania na chłoniaka Hodgkina i stwardnienie rozsiane. ostatnie doniesienia potwierdziły dowody na to, że wirus Epsteina-Barra (EBV) jest czynnikiem etiologicznym stwardnienia rozsianego.
Mononukleoza zakaźna (IM) jest zespołem wywoływanym głównie przez wirus Epsteina-Barr (EBV). Za potencjalne czynniki etiologiczne mononukleozy uważa się również inne patogeny:
- CMV – wirus cytomegalii, który może być przczyną nawet 7% przypadków mononukleozy
- ludzki herpeswirus 6 (HHV-6)
- adenowirus
- wirus opryszczki pospolitej.
Również Streptococcus pyogenes i Toxoplasma gondii uznawane są za potencjalne czynniki etiologiczne tej choroby.
Wirus ten nie jest bardzo zaraźliwy, przenosi się głównie ze śliną (choroba pocałunków). Osoby z infekcją utajoną mogą przenosić zakażenie, dlatego właściwie nie ma możliwości zapobiegania rozsiewowi. Rozpoznanie IM opiera się na objawach klinicznych, takich jak ból gardła, gorączka, powiększenie węzłów chłonnych i osłabienie, w połączeniu z wynikami badań laboratoryjnych.
Mononukleoza zakaźna (IM) jest zespołem wywoływanym głównie przez wirus Epsteina-Barr (EBV), chociaż inne czynniki zakaźne, w tym wirus cytomegalii (CMV), ludzki herpeswirus 6 (HHV-6), adenowirus, wirus opryszczki pospolitej, Streptococcus pyogenes i Toxoplasma gondii, są również uznawane za potencjalne czynniki etiologiczne. Spośród nich najczęstszym z nich jest CMV, który może być przyczyną nawet 7% przypadków zespołów mononukleozy. Metodą z wyboru w diagnostyce IM pozostaje serologia.
Mononukleoza – objawy
Infekcje występujące we wczesnym dzieciństwie charakteryzują się najczęściej bardzo łagodnymi objawami lub zupełnym ich brakiem. Natomiast w okresie dojrzewania lub u młodych dorosłych często rozwijają się objawy mononukleozy zakaźnej.
W typowym przebiegu IM początkowo występują objawy nieswoiste. Pacjenci skarżą się na:
- zmęczenie,
- brak apetytu,
- bóle mięśni.
Po kilku dniach (do tygodnia) pojawiają się kolejne objawy:
- gorączka 39-40°C (u 90% pacjentów),
- powiększenie szyjnych węzłów chłonnych (90%),
- rozlane wysiękowe zapalenie gardła (33%),
- wysypka (5%).
U około połowy pacjentów stwierdza się splenomegalię – powiekszenie śledziony, która zwykle pojawia się w drugim lub trzecim tygodniu choroby. Powiększona może być również wątroba, ale zdarza się to rzadko. Choroba trwa zazwyczaj 2-3 tygodnie, ale zmęczenie może utrzymywać się jeszcze nawet przez kilka miesięcy.
Diagnostyka mononukleozy
U większości pacjentów z niepowikłaną mononukleozą do diagnostyki w zupełności wystarczy wykonanie morfologii krwi obwodowej z mikroskopową oceną rozmazu i test na obecność przeciwciał heterofilnych. Na zakażenie wirusem Epsteina-Barra (EBV) może wskazywać obecność limfocytów reaktywnych wraz z bezwzględną limfocytozą.

Charakterystyczne wyniki morfologii krwi obwodowej u pacjentów zakażonych wirusem Epsteina-Barra (EBV):
- Reaktywne limfocyty
Już w pierwszym tygodniu choroby można zaobserwować wzrost całkowitej liczby krwinek białych z przewagą limfocytów (limfocyty są duże, z nieregularnym jądrem, stanowią co najmniej 10% wszystkich leukocytów. Są to aktywowane limfocyty T (CD8), powstałe w odpowiedzi na obecność w organizmie zakażonych limfocytów B
- Nieznaczna małopłytkowość 100-200tys/mm³(25-50% chorych)
- Nieswoisty obraz – leukopenia z granulocytopenią pierwsze dni po ustąpieniu objawów
Główne grupy testów
Testy nieswoiste
Odczyn Paula – Bunnella – Davidsohna:
Nieswoiste przeciwciała heterofilne (głównie IgM; odczyn Paula, Bunnella i Davidsohna, szybkie testy aglutynacyjne) – pomocne w razie niedostępności swoistych testów serologicznych; pojawiają się pod koniec 2. tyg. i w 3 tyg. choroby (u 80–90% dorosłych chorych) i dość szybko zanikają (nawet po upływie 1 miesiąca). W przypadku dodatniego wyniku dalsza diagnostyka nie jest zwykle konieczna (czułość ~75%, swoistość ~90%). U dzieci <12. r.ż. mogą nie występować, dlatego ujemny wynik testu nie wyklucza choroby, należy wtedy u nich poszukiwać przeciwciał swoistych.
Wykrywanie swoistych IgM, narzędzia z wyboru w przypadku większości zakażeń wirusowych, jest skomplikowane w przypadku zakażeń wirusem Epsteina-Barr (EBV) ze względu na wysoki stopień reakcji krzyżowej z innymi herpeswirusami powodującymi IM, takimi jak CMV i HHV-6 . Ponadto w przypadku IM poliklonalna stymulacja limfocytów pamięci może być odzwierciedlona jako dodatnia szeroka reaktywność IgM. W związku z tym potrzebne są profile przeciwciał do uzyskania skutecznej diagnostyki serologicznej zakażenia wirusem Epsteina-Barra (EBV). Głównymi markerami swoistymi dla wirusa są przeciwciała IgM i IgG w odpowiedzi na antygen kapsydu wirusa (VCA) oraz przeciwciała przeciwko antygenowi jądrowemu wirusa Epsteina-Barr (EBV) (EBNA), zgodnie z dobrze ustalonymi kryteriami.
Testy swoiste
- Przeciwciała skierowane przeciwko antygenowi kapsydowemu wirusa Epsteina-Barra (EBV) (viral capsid antigen – VCA)
- Przeciwciał skierowane przeciwko antygenowi wczesnemu (early antigen – EA)
- Przeciwciał skierowane przeciwko antygenowi jądrowemu (Epstein-Barr nuclear antigen – EBNA)


Kolejność pojawiania się poszczególnych przeciwciał podczas mononukleozy
Swoiste przeciwciała przeciwko wirusowi Epsteina-Barr (EBV) – pojawiają się w następującej kolejności:
- Anty – VCA IgM
- Anty – VCA IgG
- Anty – EA
- Anty – EBNA
Ad-1, Ad-2: przeciwko antygenowi kapsydowemu:
anty-VCA IgM – pojawiają się najwcześniej (w 2 tyg.), nawet u 95% ze świeżym zakażeniem, miano szybko się zwiększa w ciągu kilku dni od początku ostrej fazy zakażenia; zanikają w ciągu 2–3 mies.;
anty-VCA IgG – pojawiają 2-4 tyg od wystąpienia zakażenia wirusem Epsteina-Barra (EBV), w praktyce świadczą o przebytym zakażeniu (nie są przydatne do wykrywania ostrej fazy zakażenia), utrzymują się przez całe życie
Ad-3: przeciwko wczesnemu antygenowi:
anty-EA – pojawiają się w ostrej fazie zakażenia, zwykle są niewykrywalne po upływie 3–6 mies. (u ~20% zakażonych mogą być wykrywalne przez kilka lat od zakażenia)
Ad-4: przeciwko antygenom jądrowym:
anty-EBNA – wytwarzane później, po kilku tygodniach (3–6), a nawet kilku miesiącach po ostrej fazie zakażenia; świadczą o przebytym zakażeniu; utrzymują się przez całe życie

Diagnostyka molekularna mononukleozy
Metody molekularne znacznie poszerzają możliwości diagnostyczne zakażeń wirusem Epsteina-Barra (EBV), szczególnie u osób w immunosupresji i chorych na nowotwory. Stosowane są różne techniki molekularne wykrywające materiał genetyczny wirusa: hybrydyzacja in situ, PCR i PCR w czasie rzeczywistym. Metody te pozwalają zarówno na wykrycie materiału genetycznego wirusa, w zakażonych komórkach, jak i na monitorowanie jego ilości. Dzięki hybrydyzacji in situ genom wirusa Epsteina-Barra (EBV) wykryto między innymi w komórkach Reeda- Sternberga i komórkach Hodgkina.
Leczenie mononukleozy
Leczenie mononukleozy ma charakter objawowy. Zalecane jest leżenie w łóżku, przyjmowanie leków przeciwgorączkowych, przeciwbólowych/przeciwzapalnych, przyjmowanie większej ilość płynów (szczególnie wysoko gorączkującym). Dieta w okresie ostrym powinna być lekkostrawna, białkowo-węglowodanowa, bogata w witaminy. W ciągu miesiąca od początku choroby zaleca się również zmniejszenie aktywność fizycznej, przede wszystkim unikanie sportów kontaktowych (zapobieganie pęknięciu powiększonej śledziony).
W większości przypadków choroba ustępuje samoistnie po 3-4 tygodniach. Ciężki, powikłany przebieg wymaga leczenia szpitalnego.
Główne konsekwencje kliniczne zakażenia wirusem Epsteina-Barr (EBV) to:
- mononukleoza zakaźna,
- chłoniak Burkita,
- potransplantacyjny zespół limfoproliferacyjny.
Artykuł zaktualizowano 15.10.2024